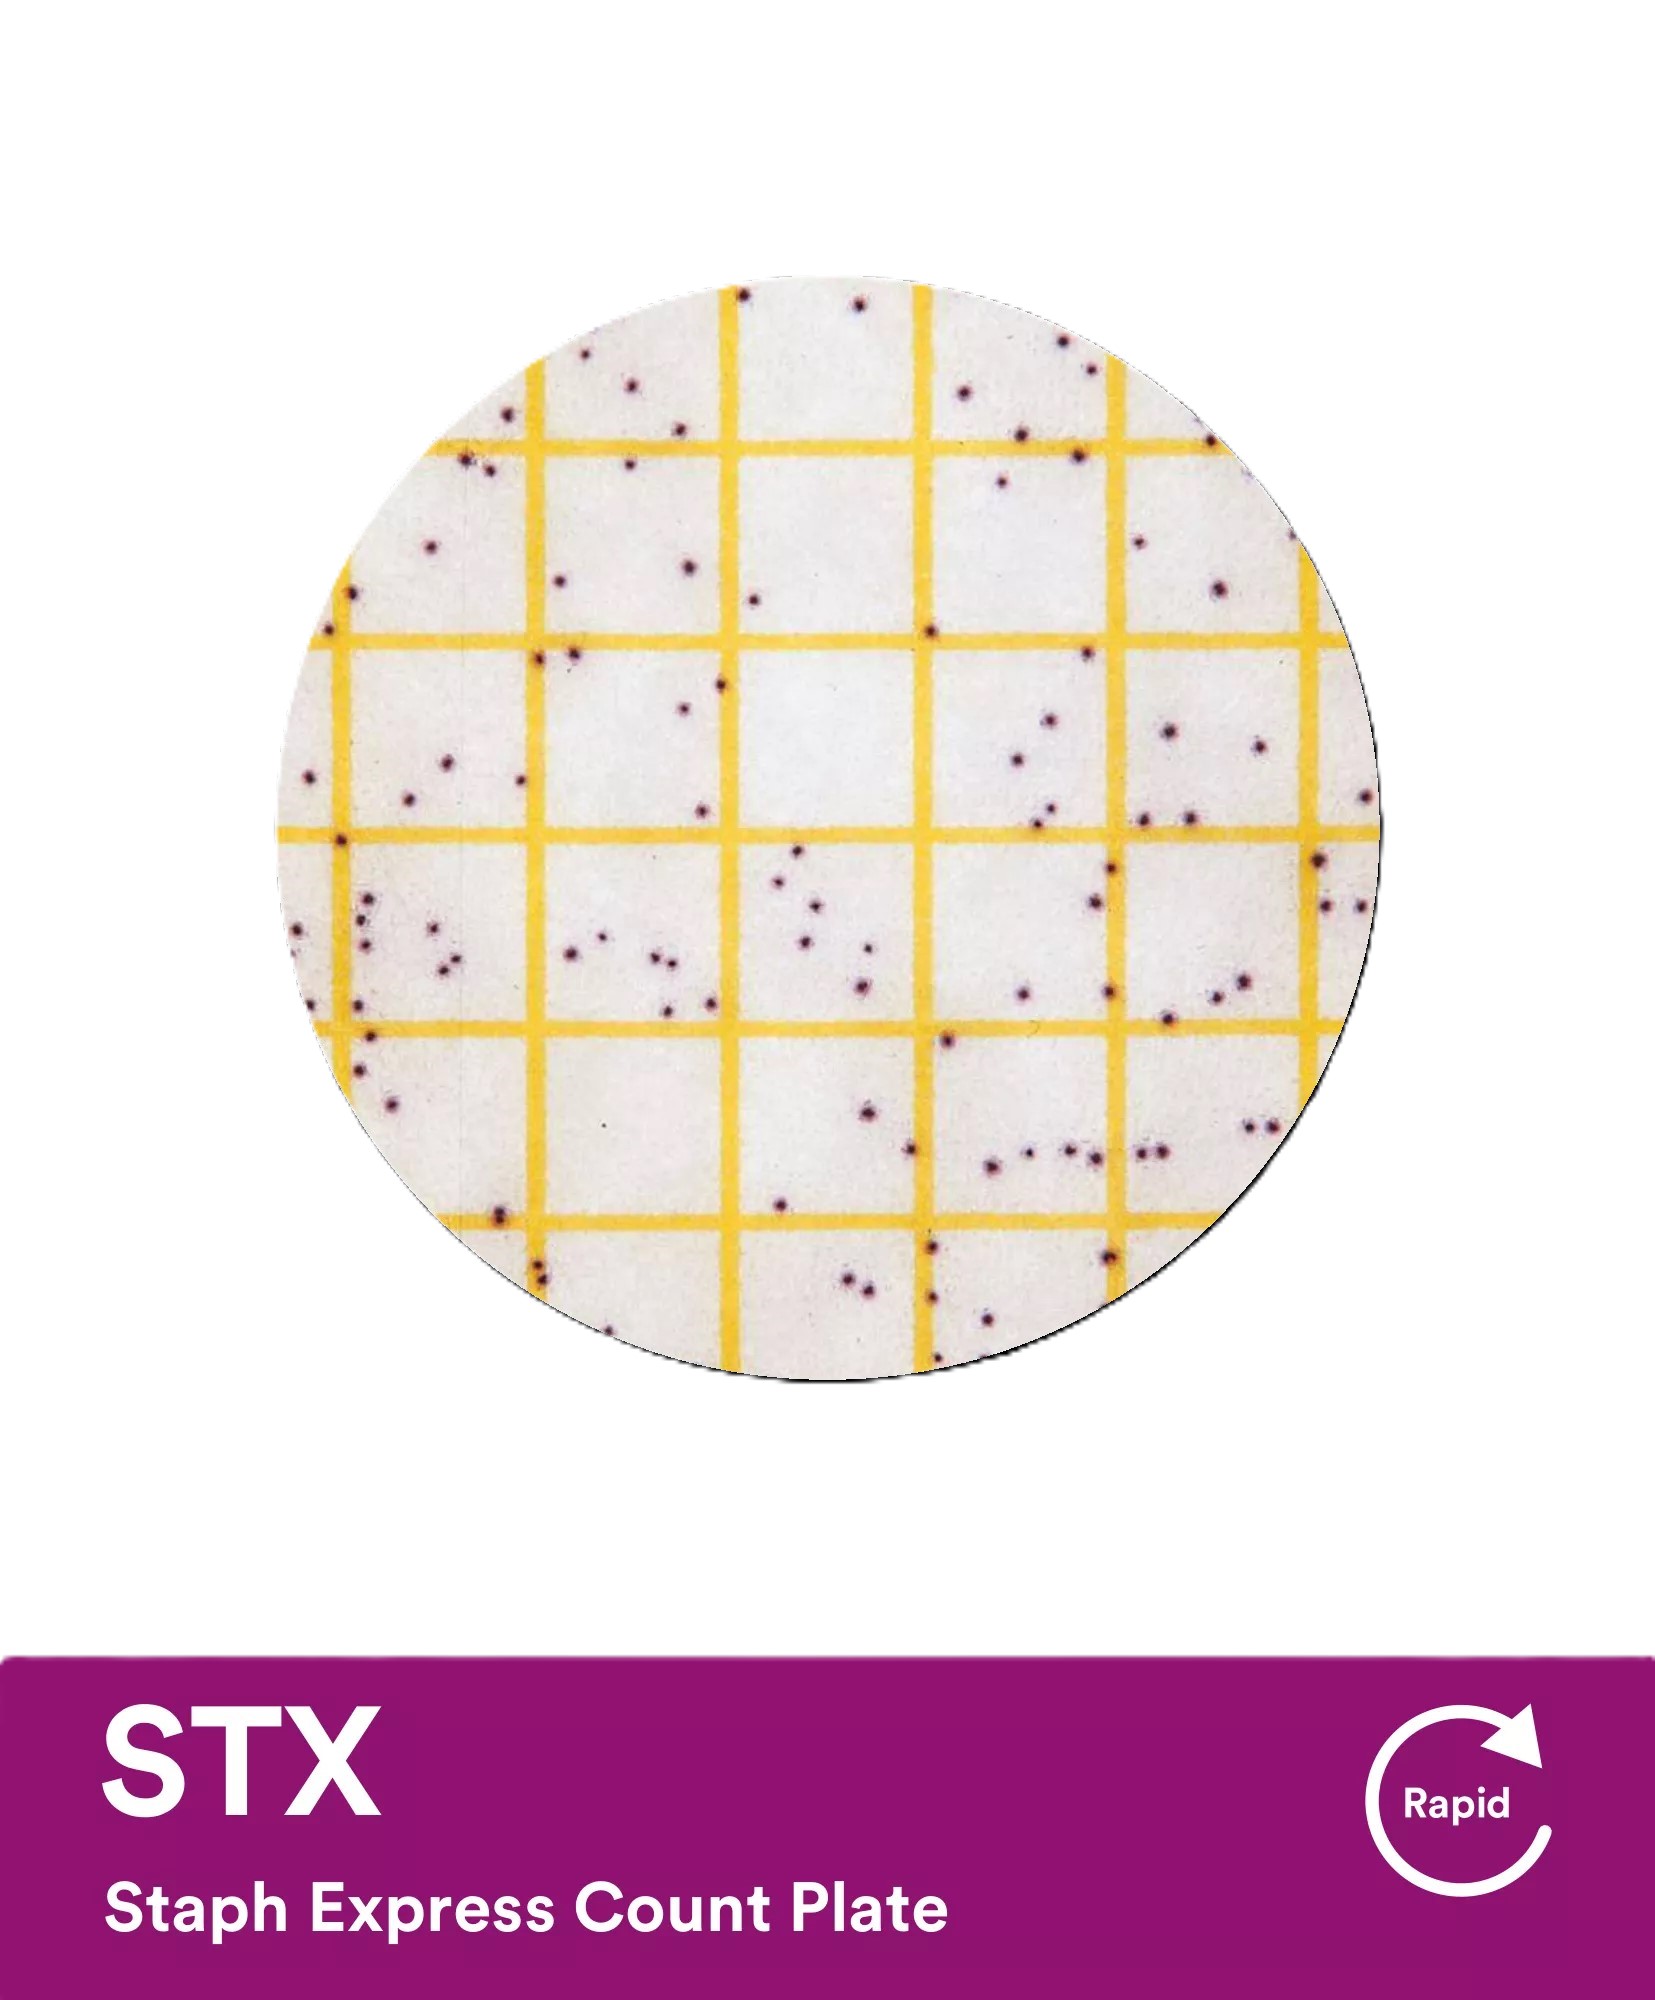
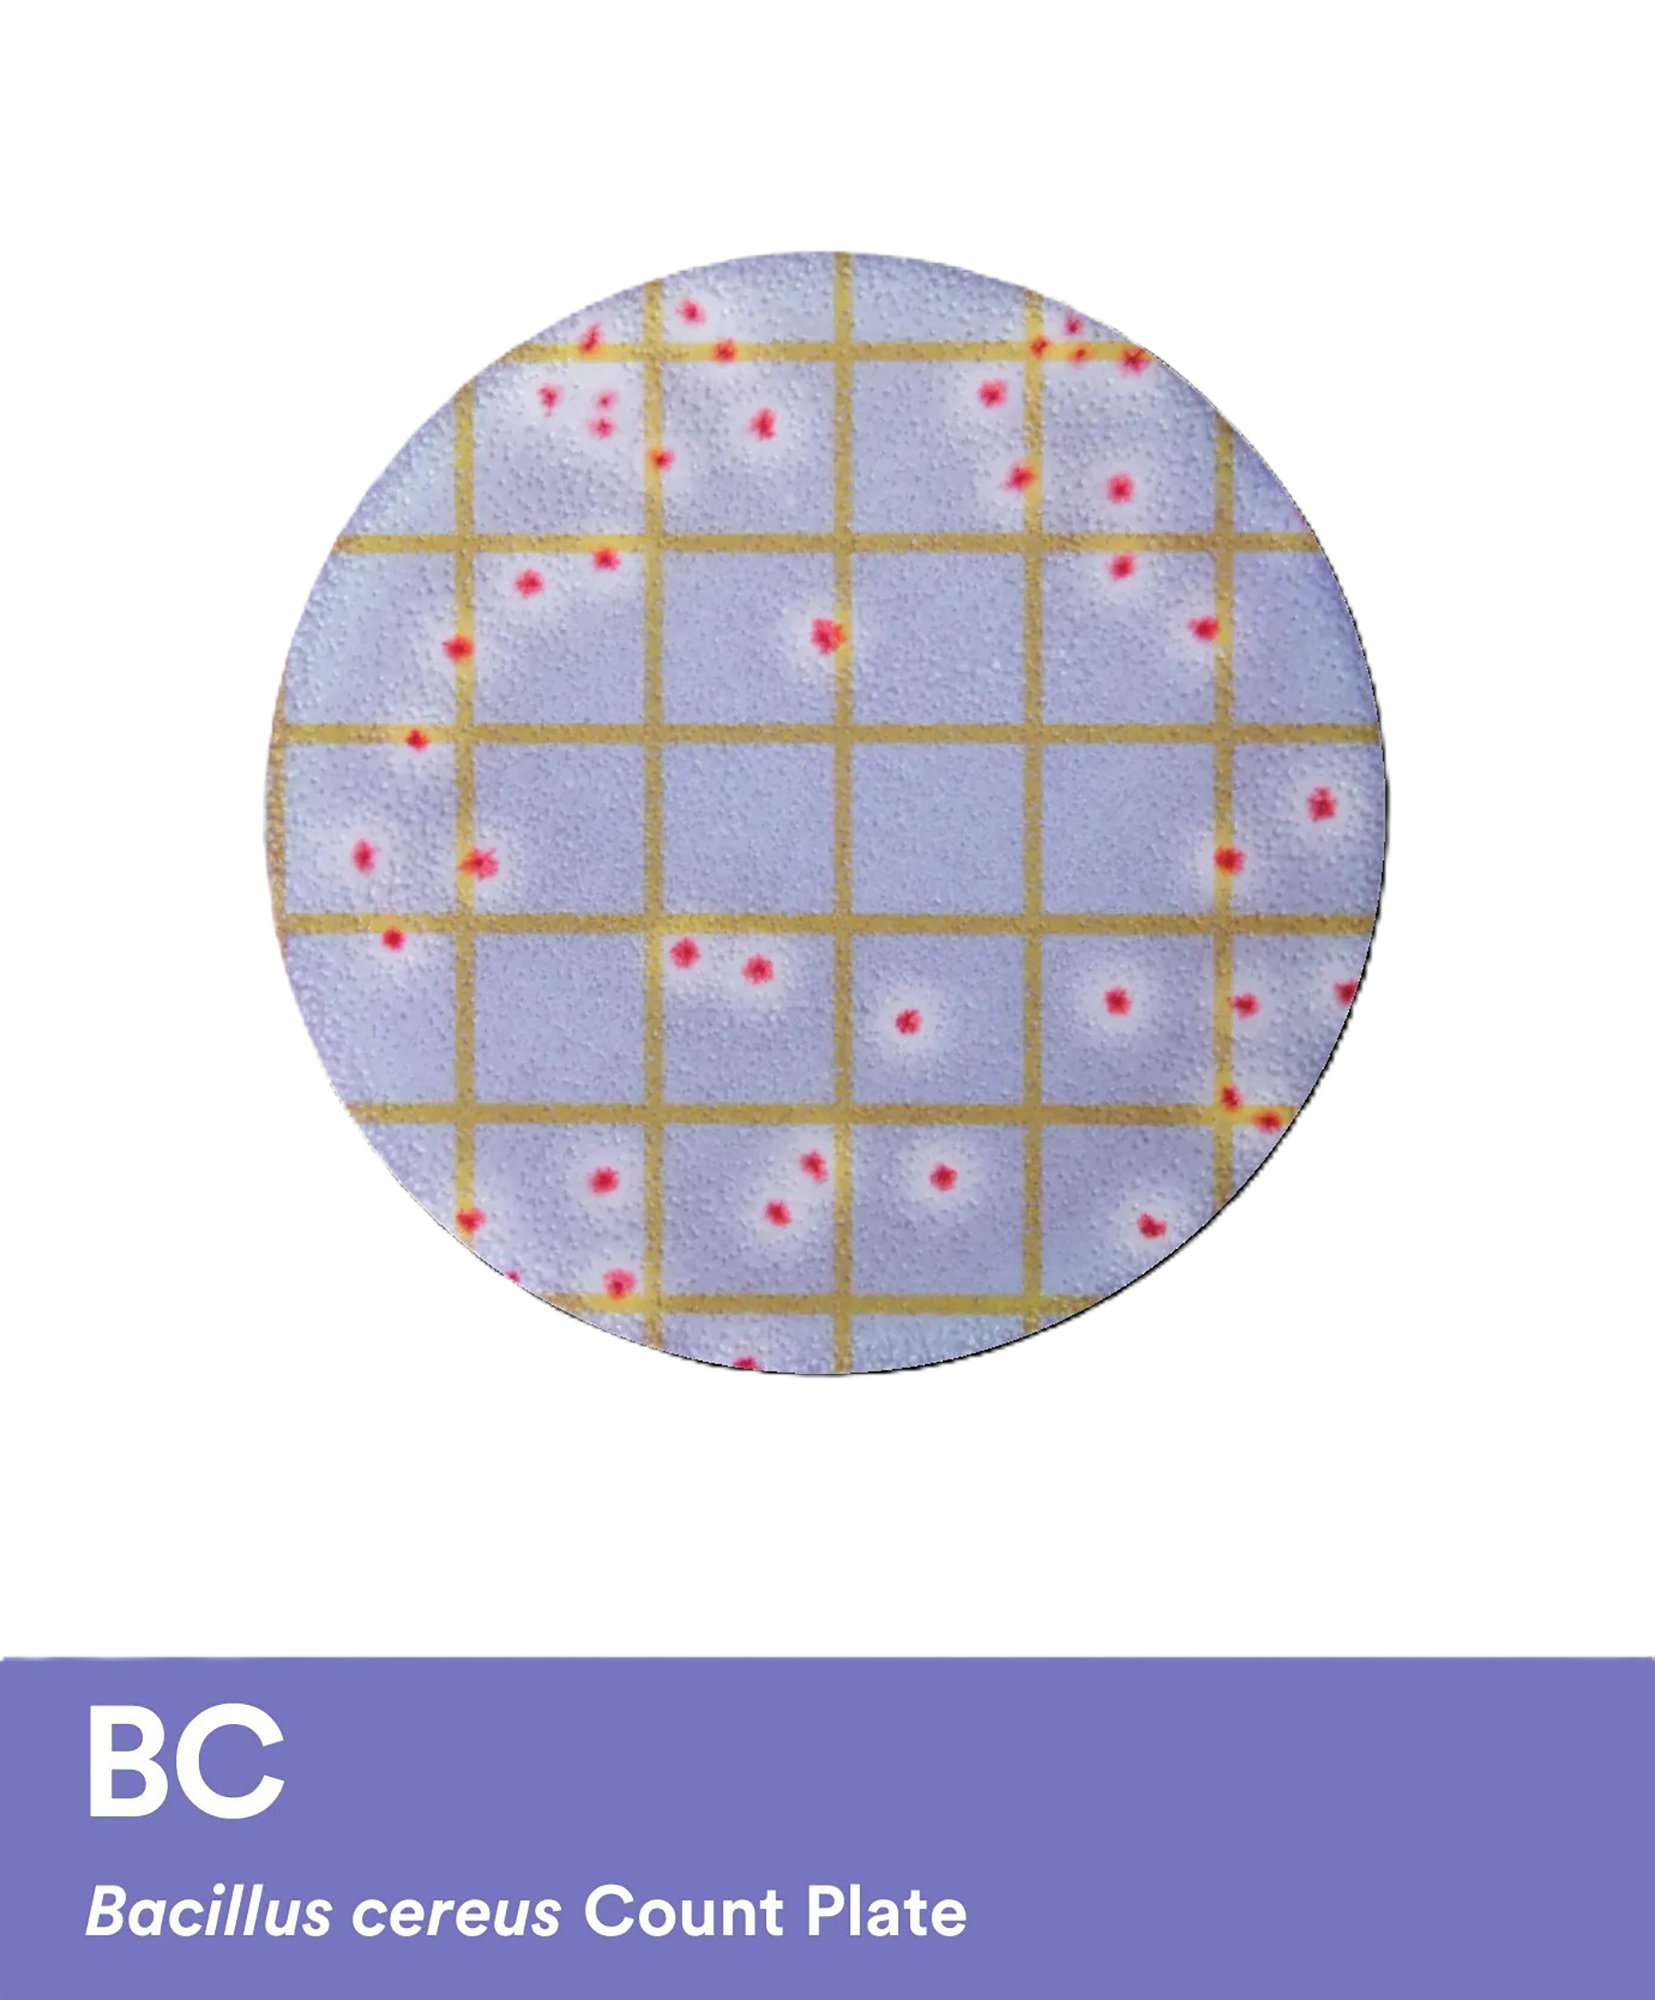
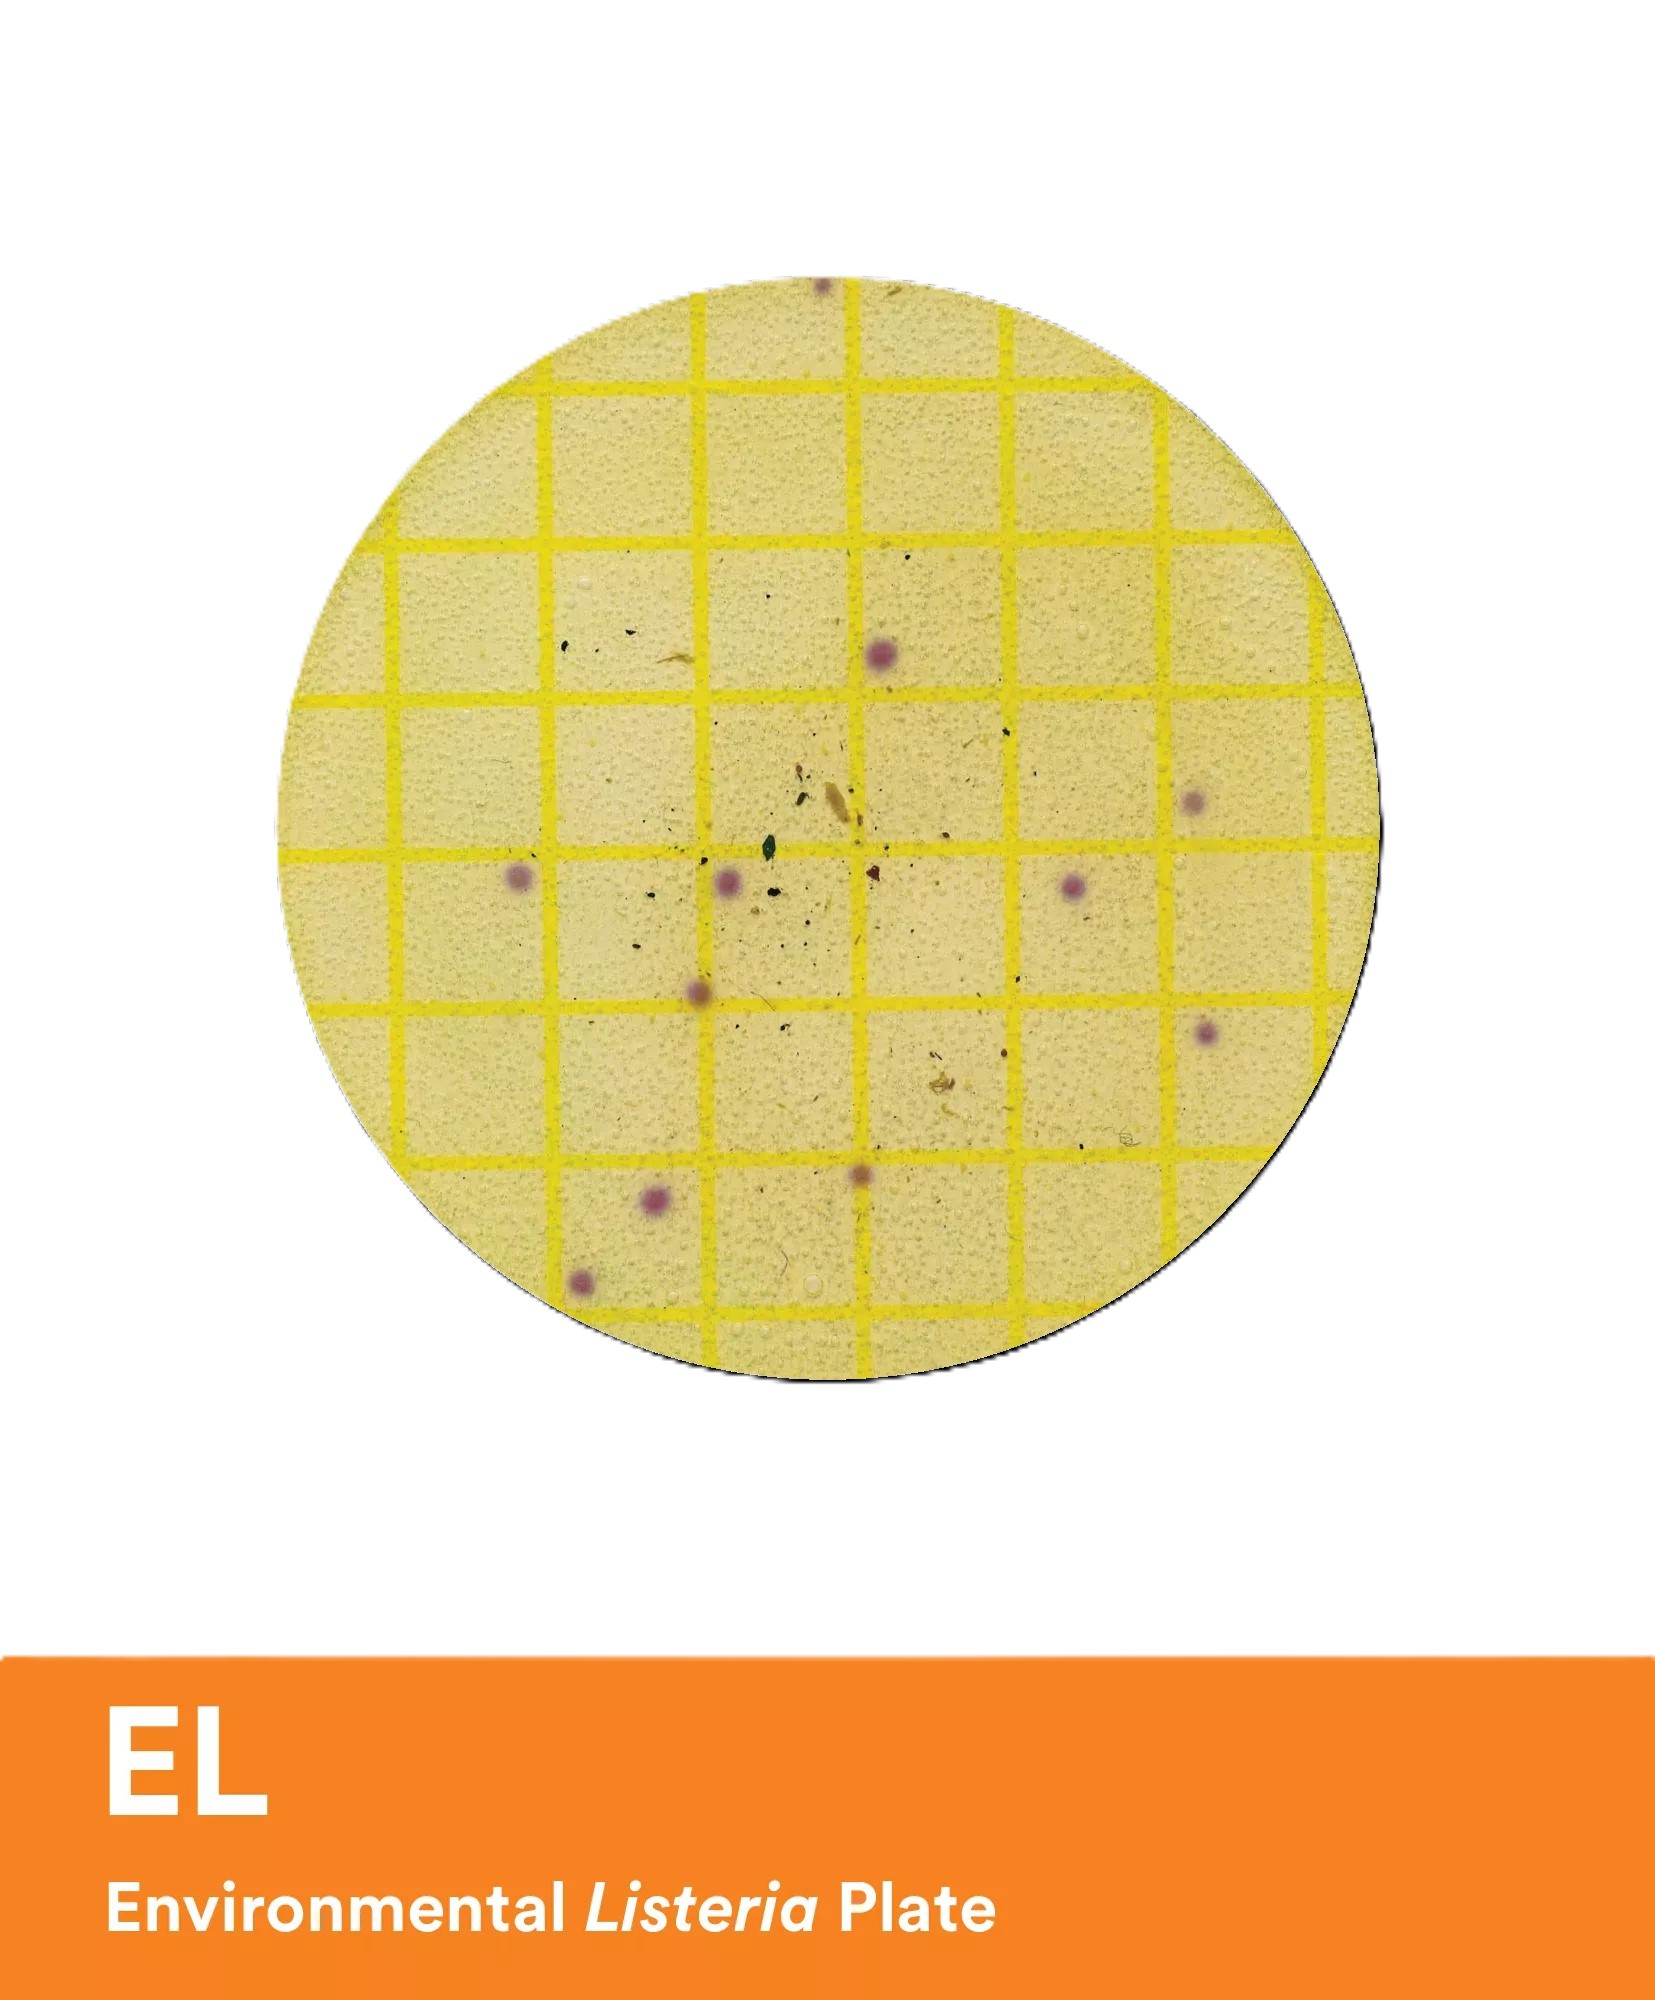
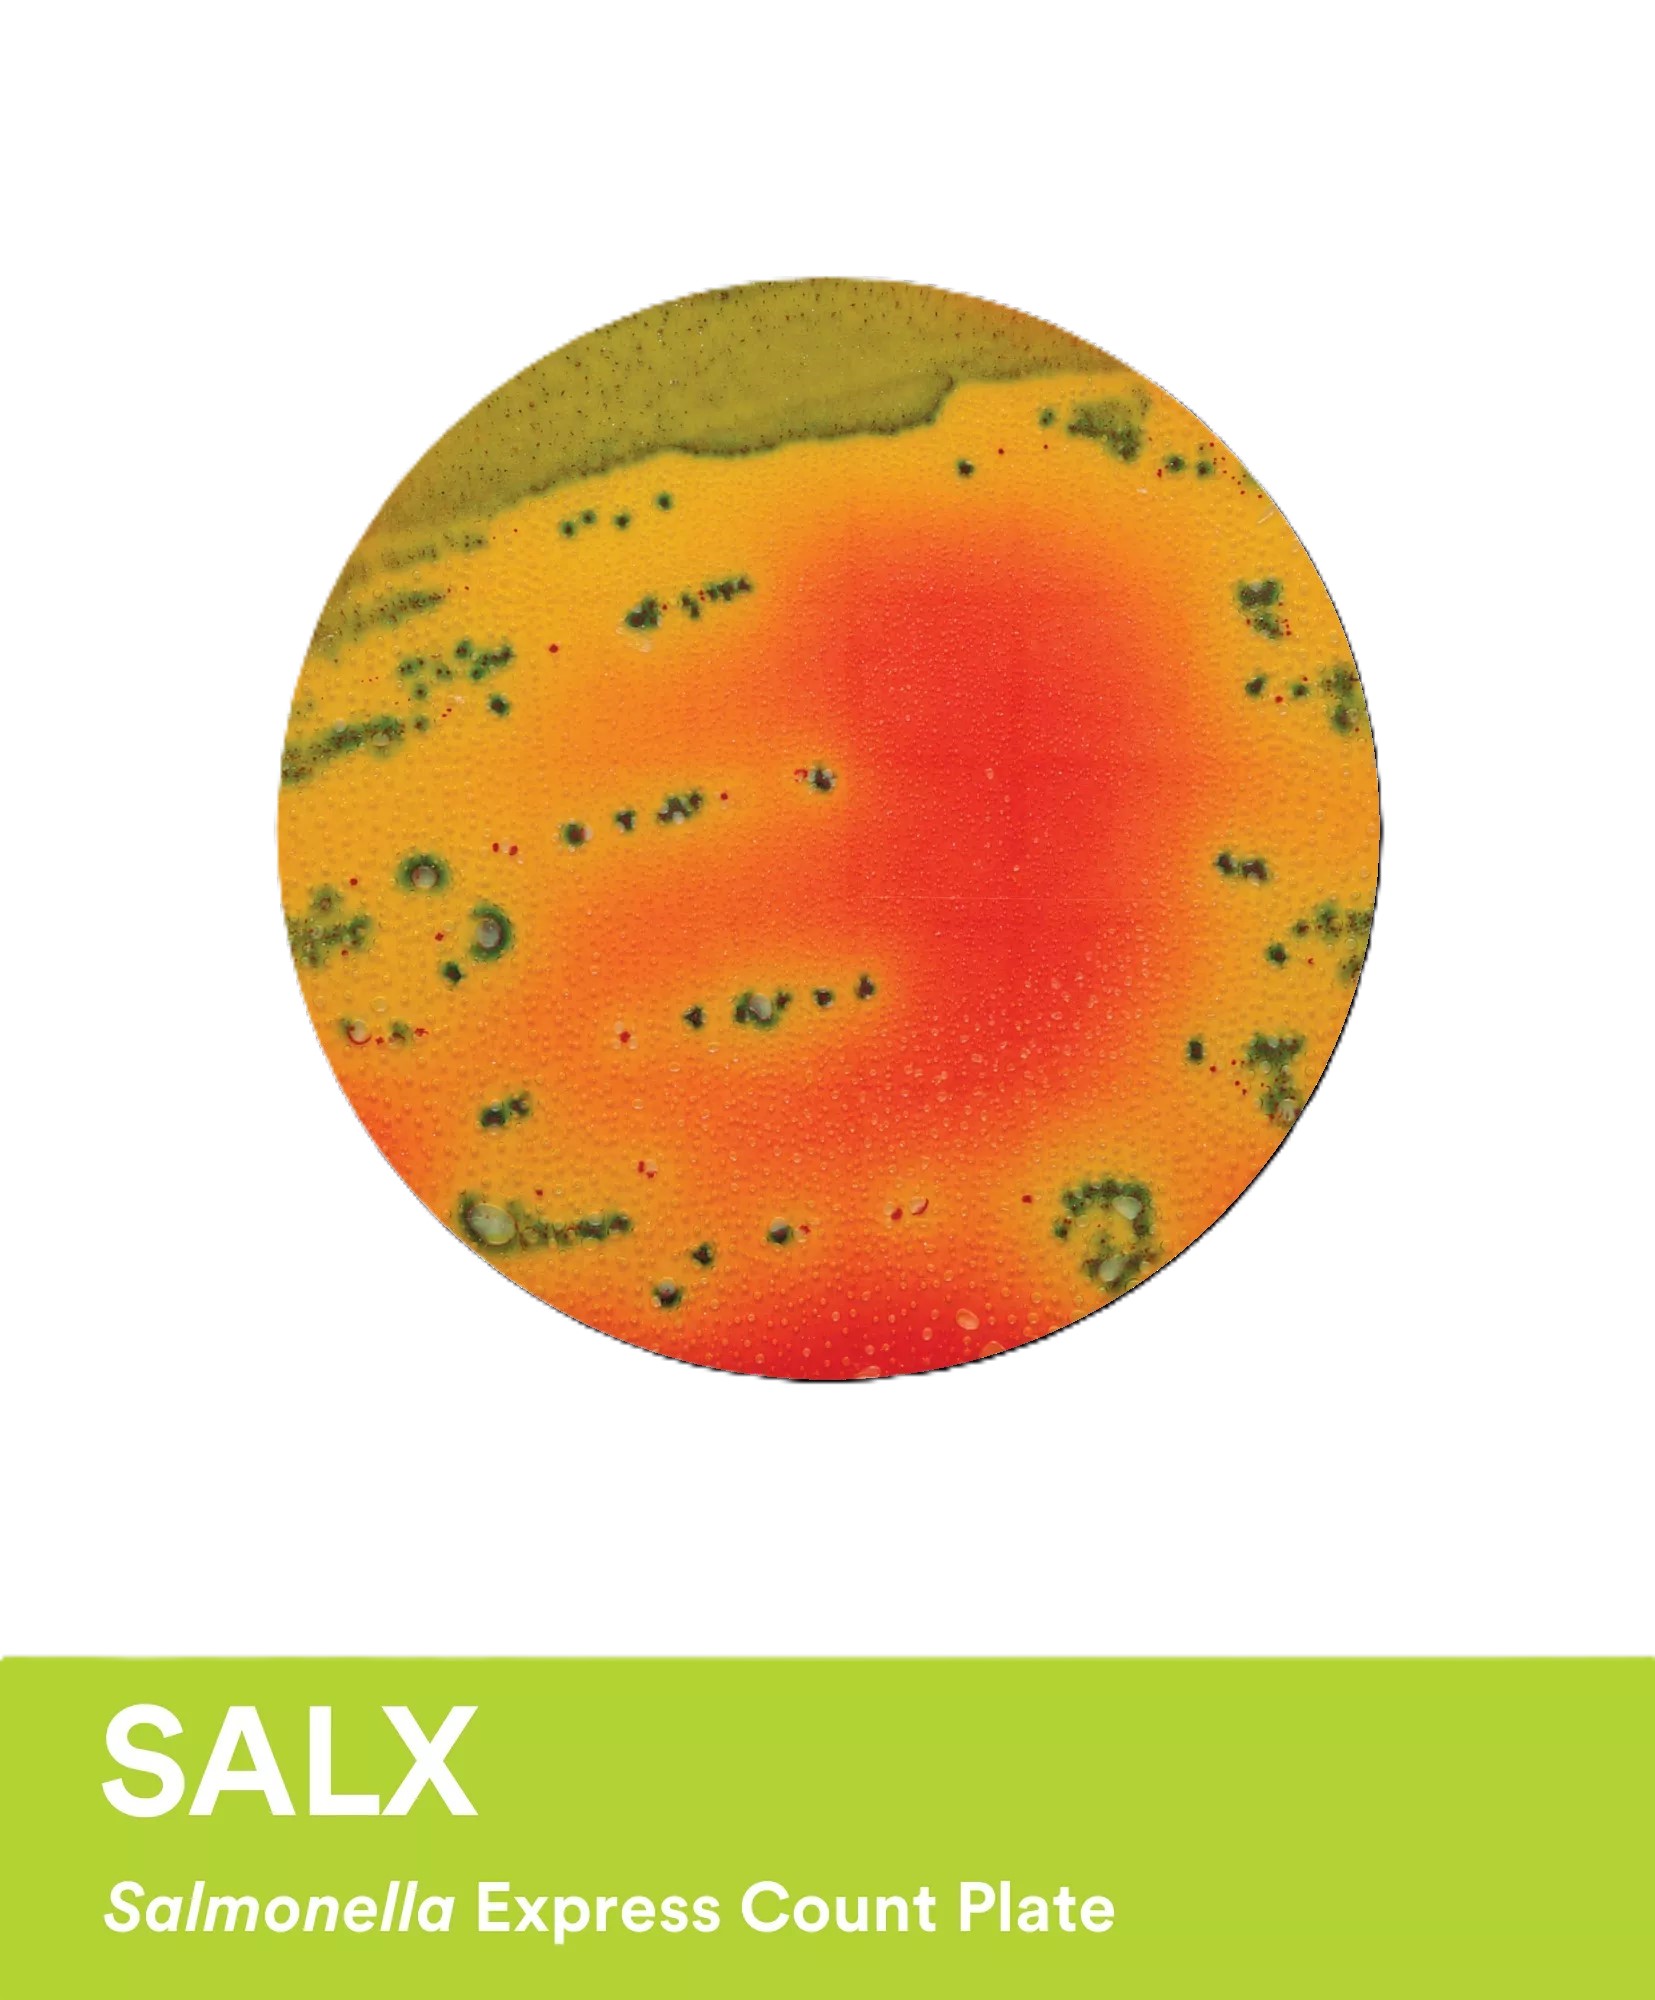
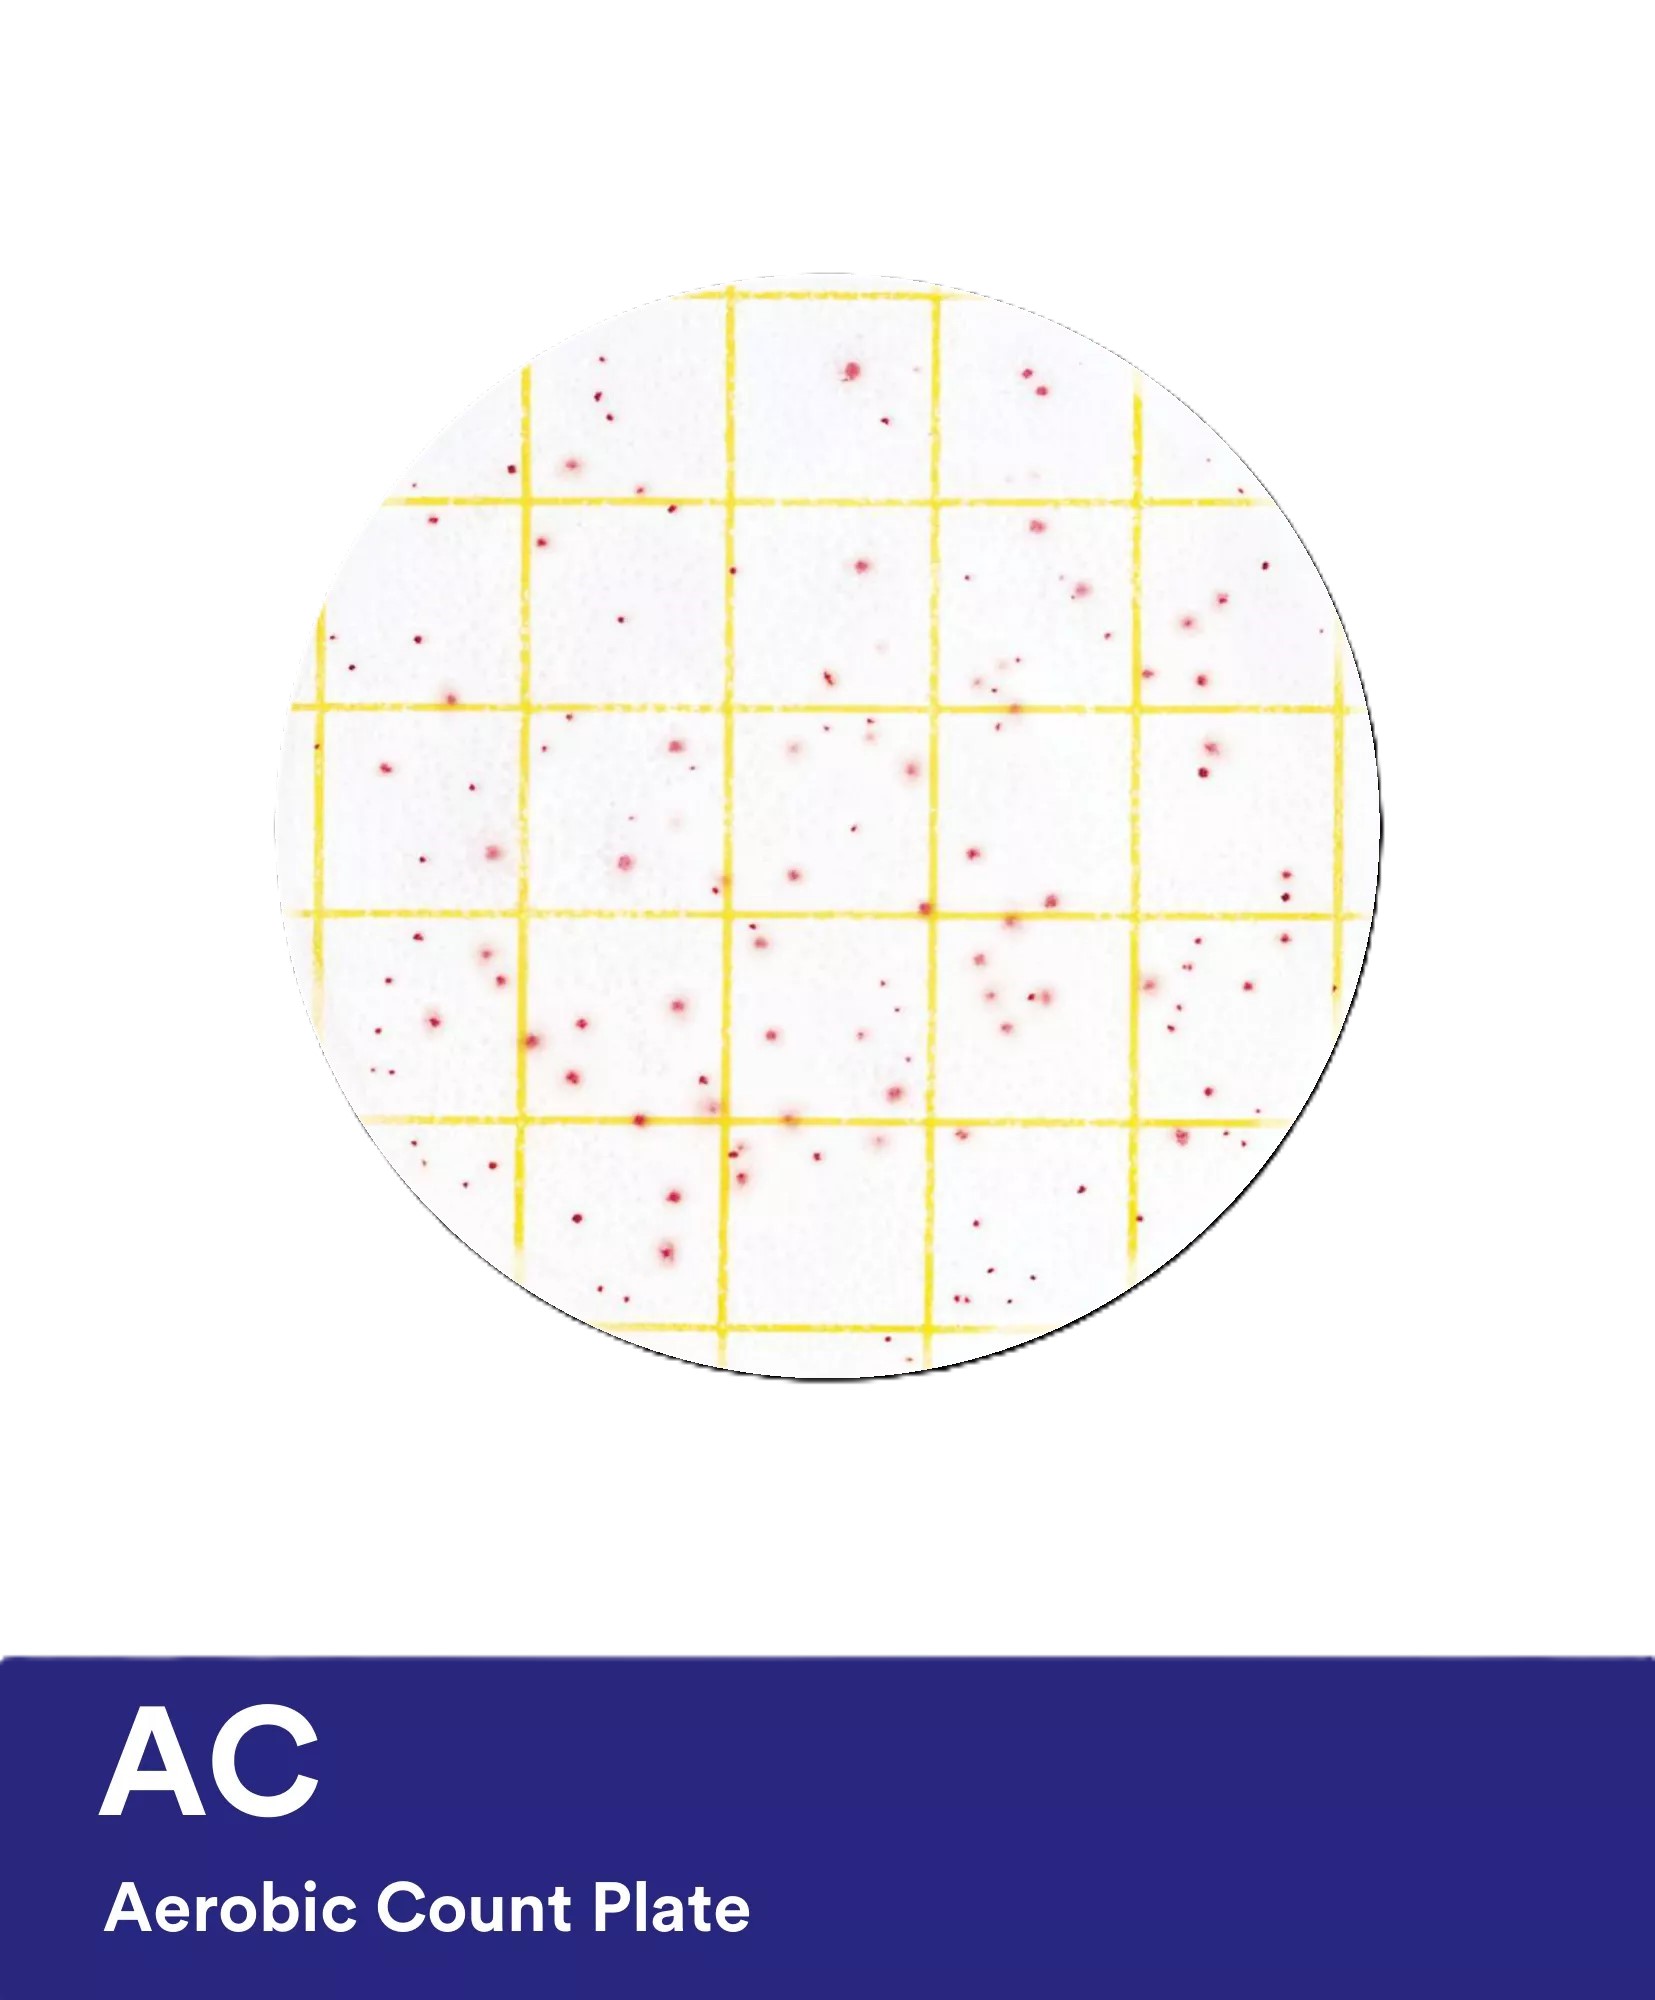
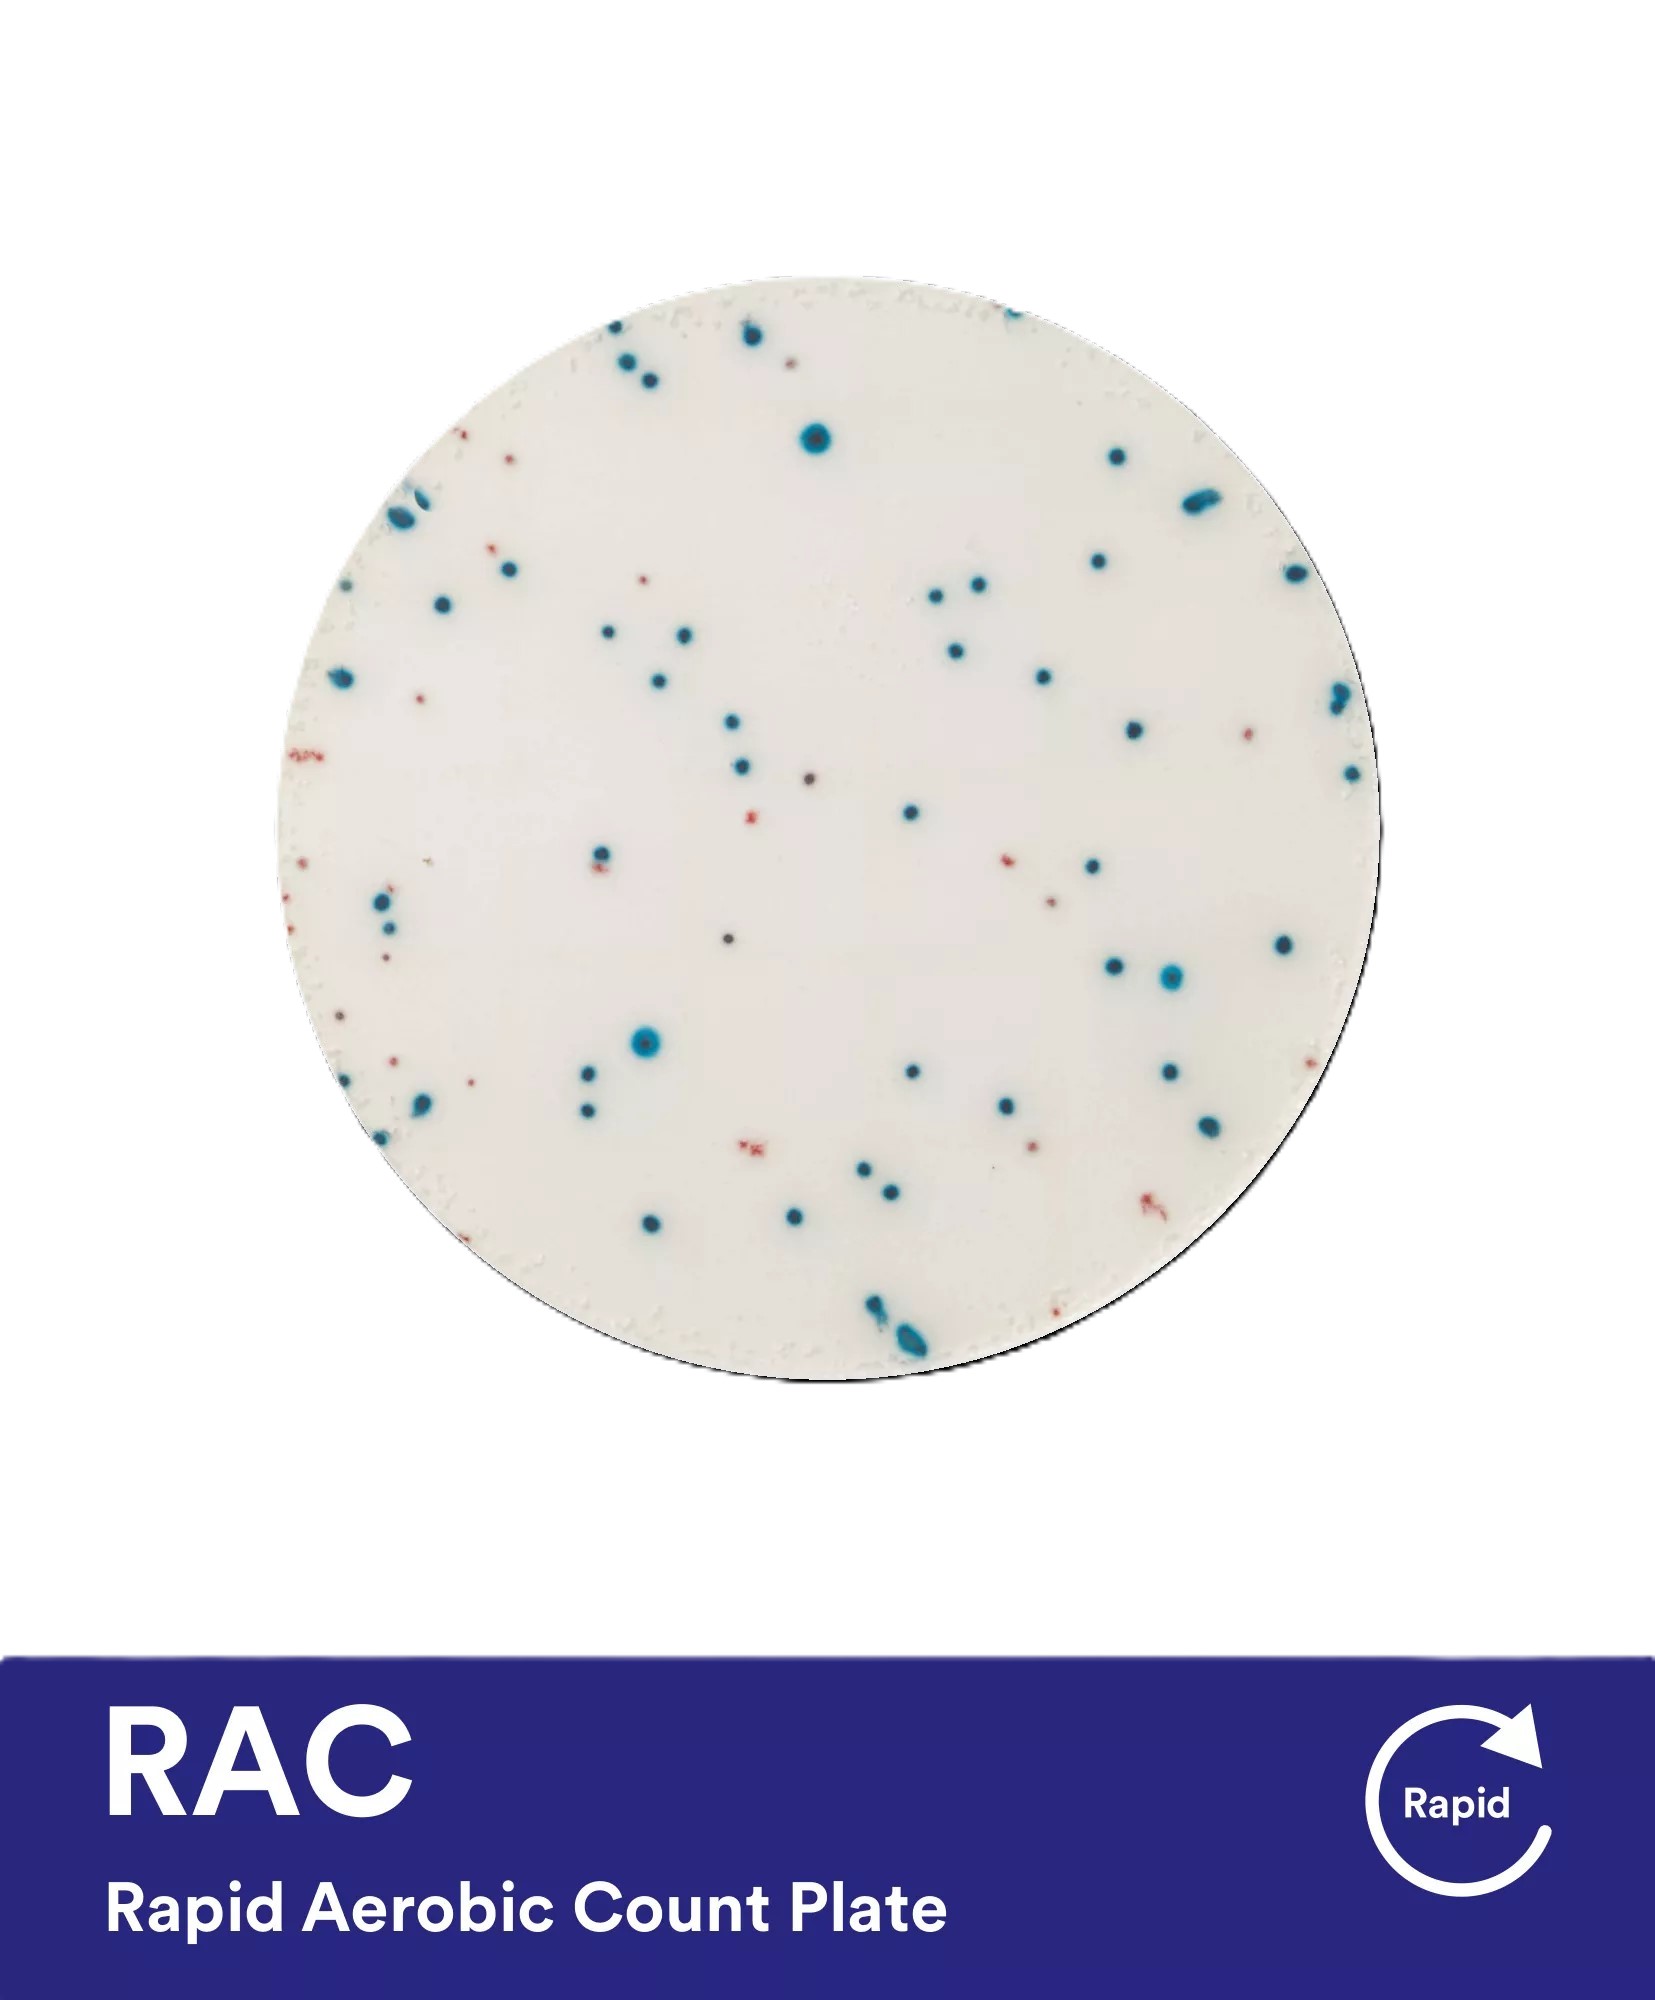
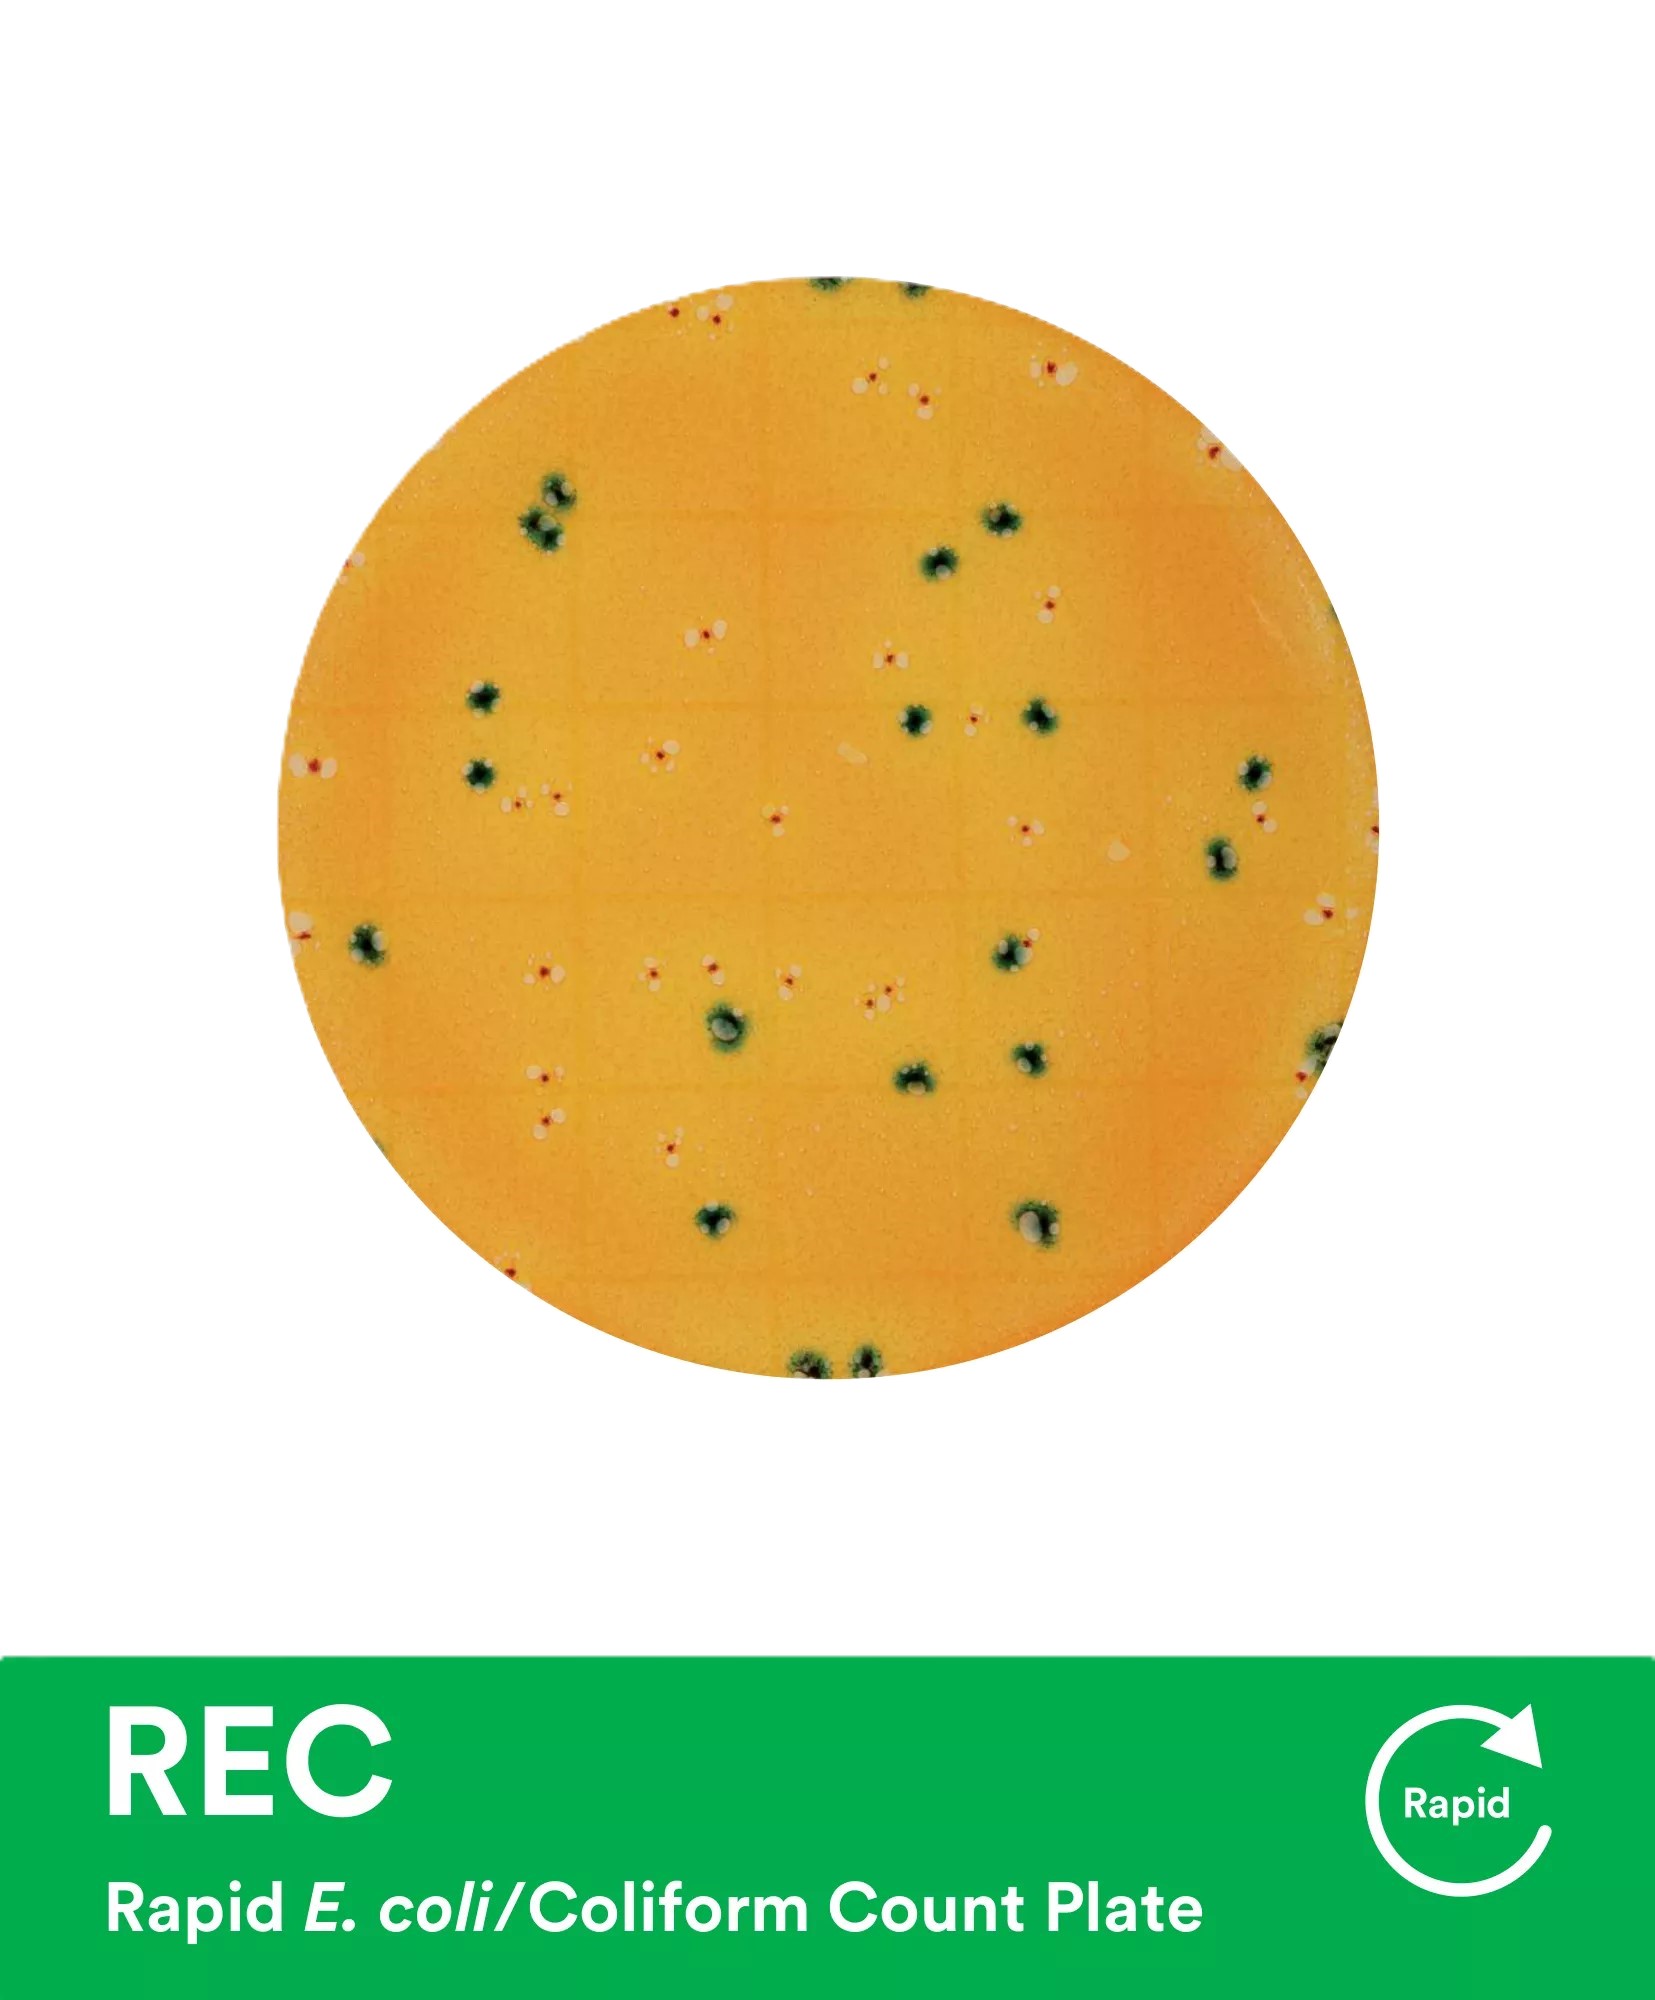
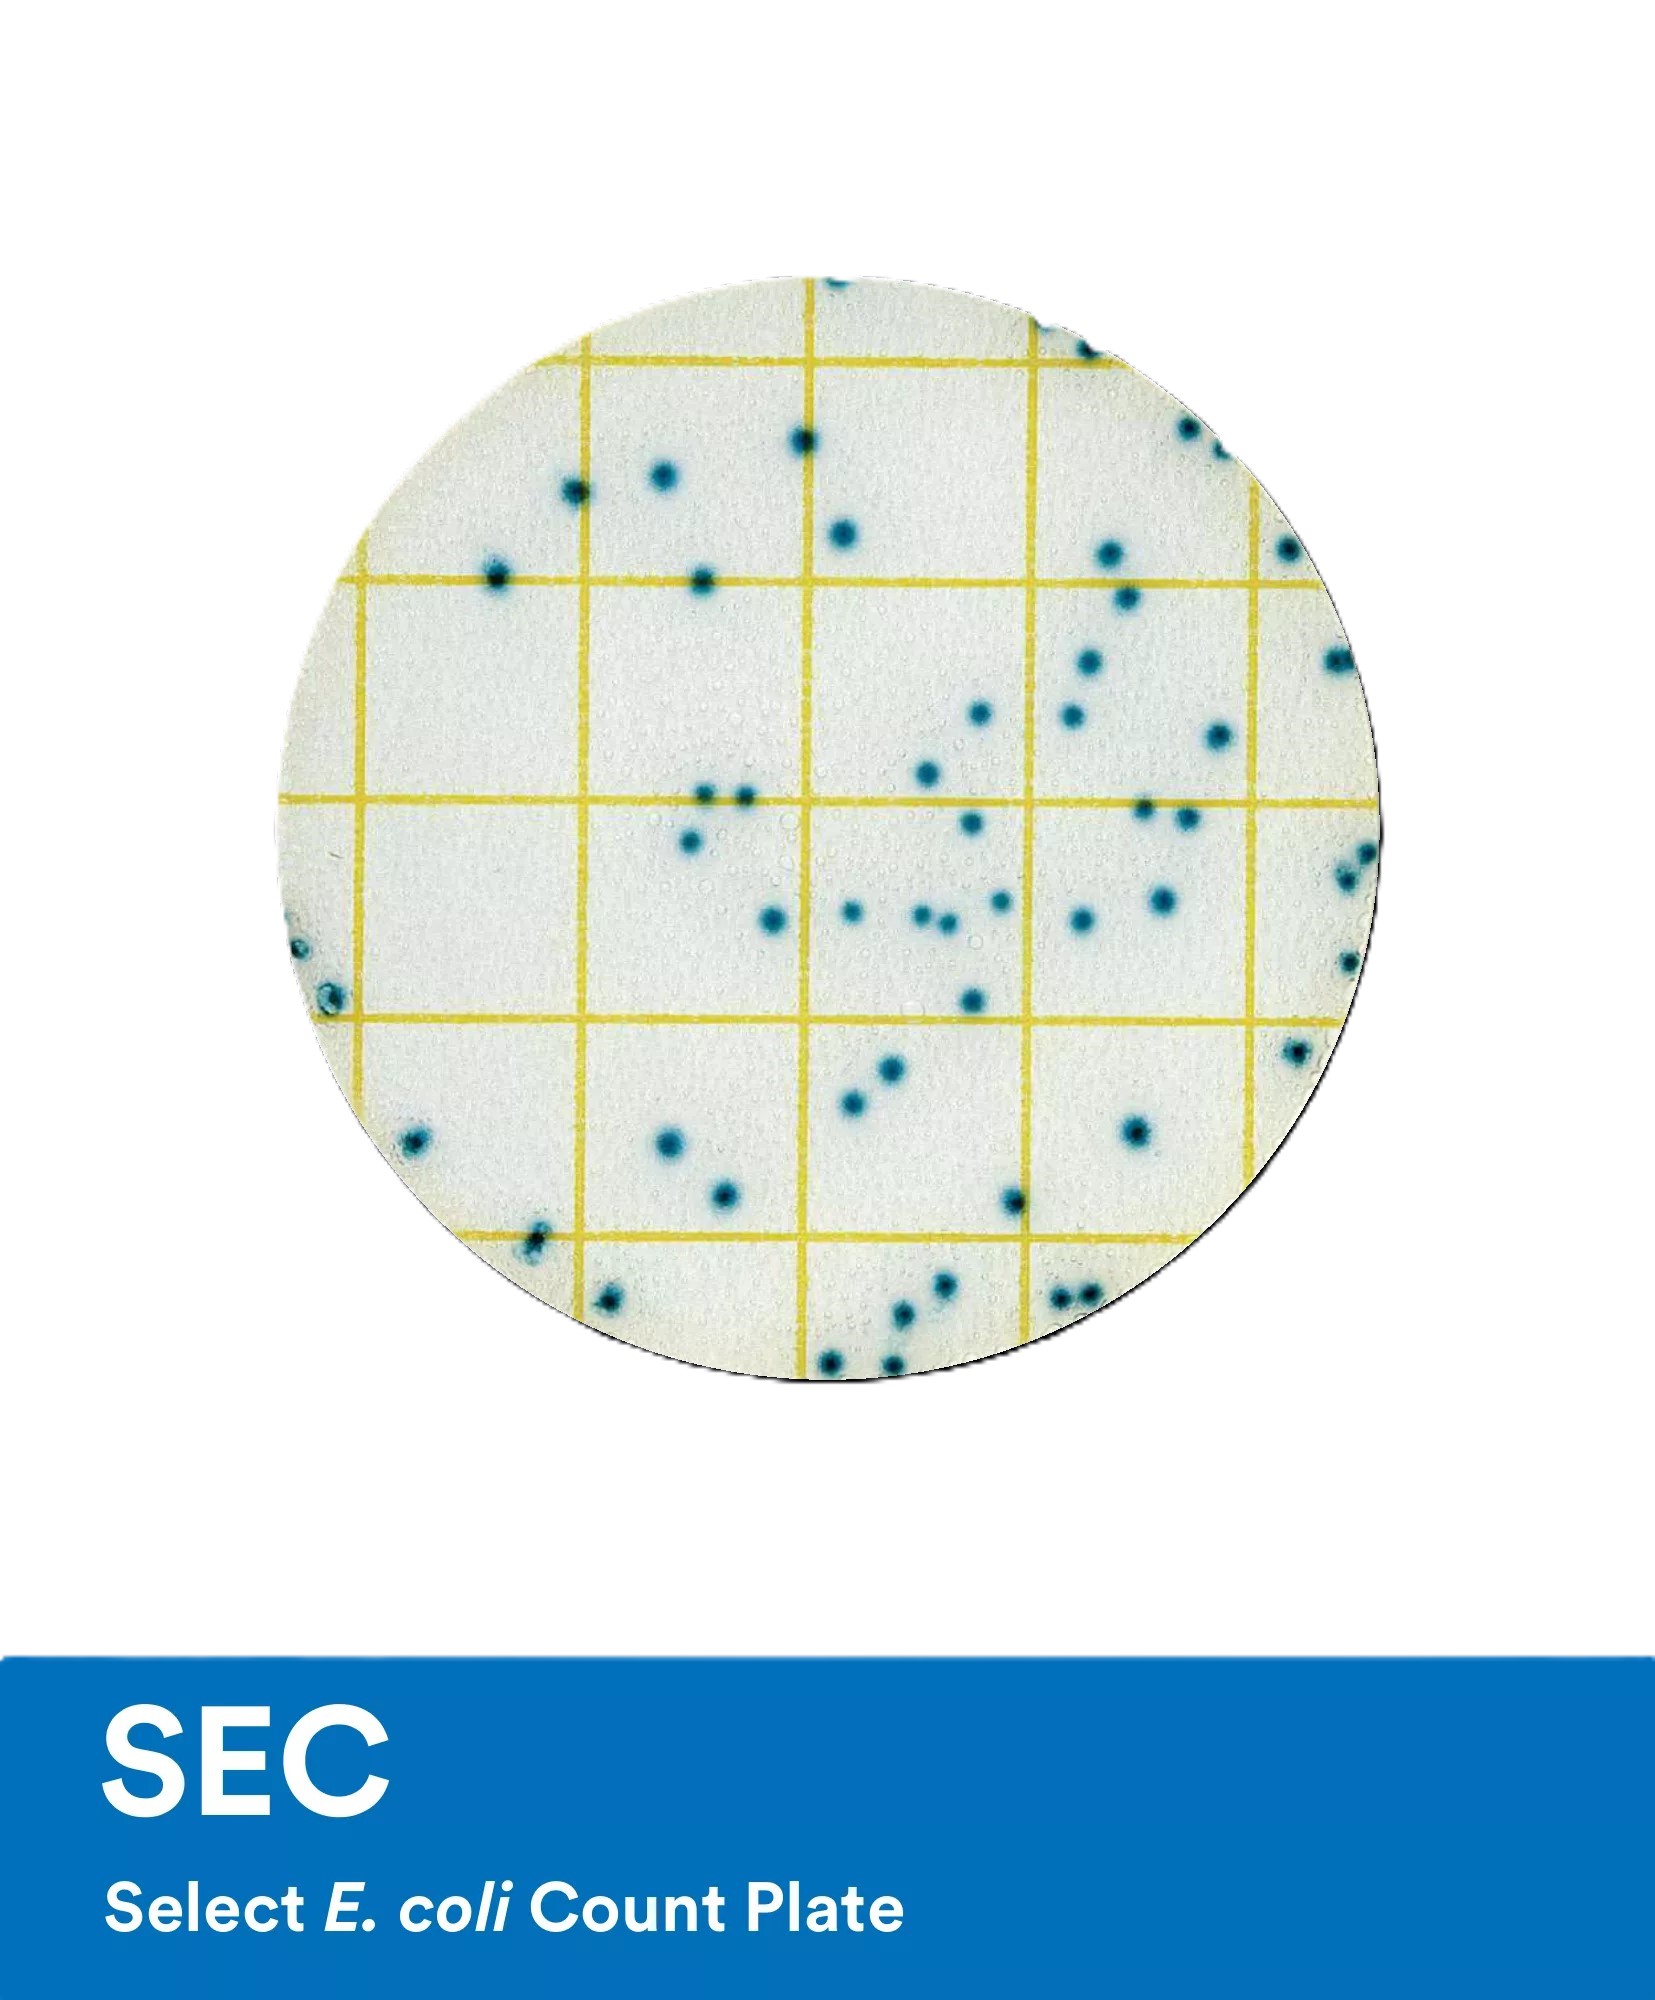
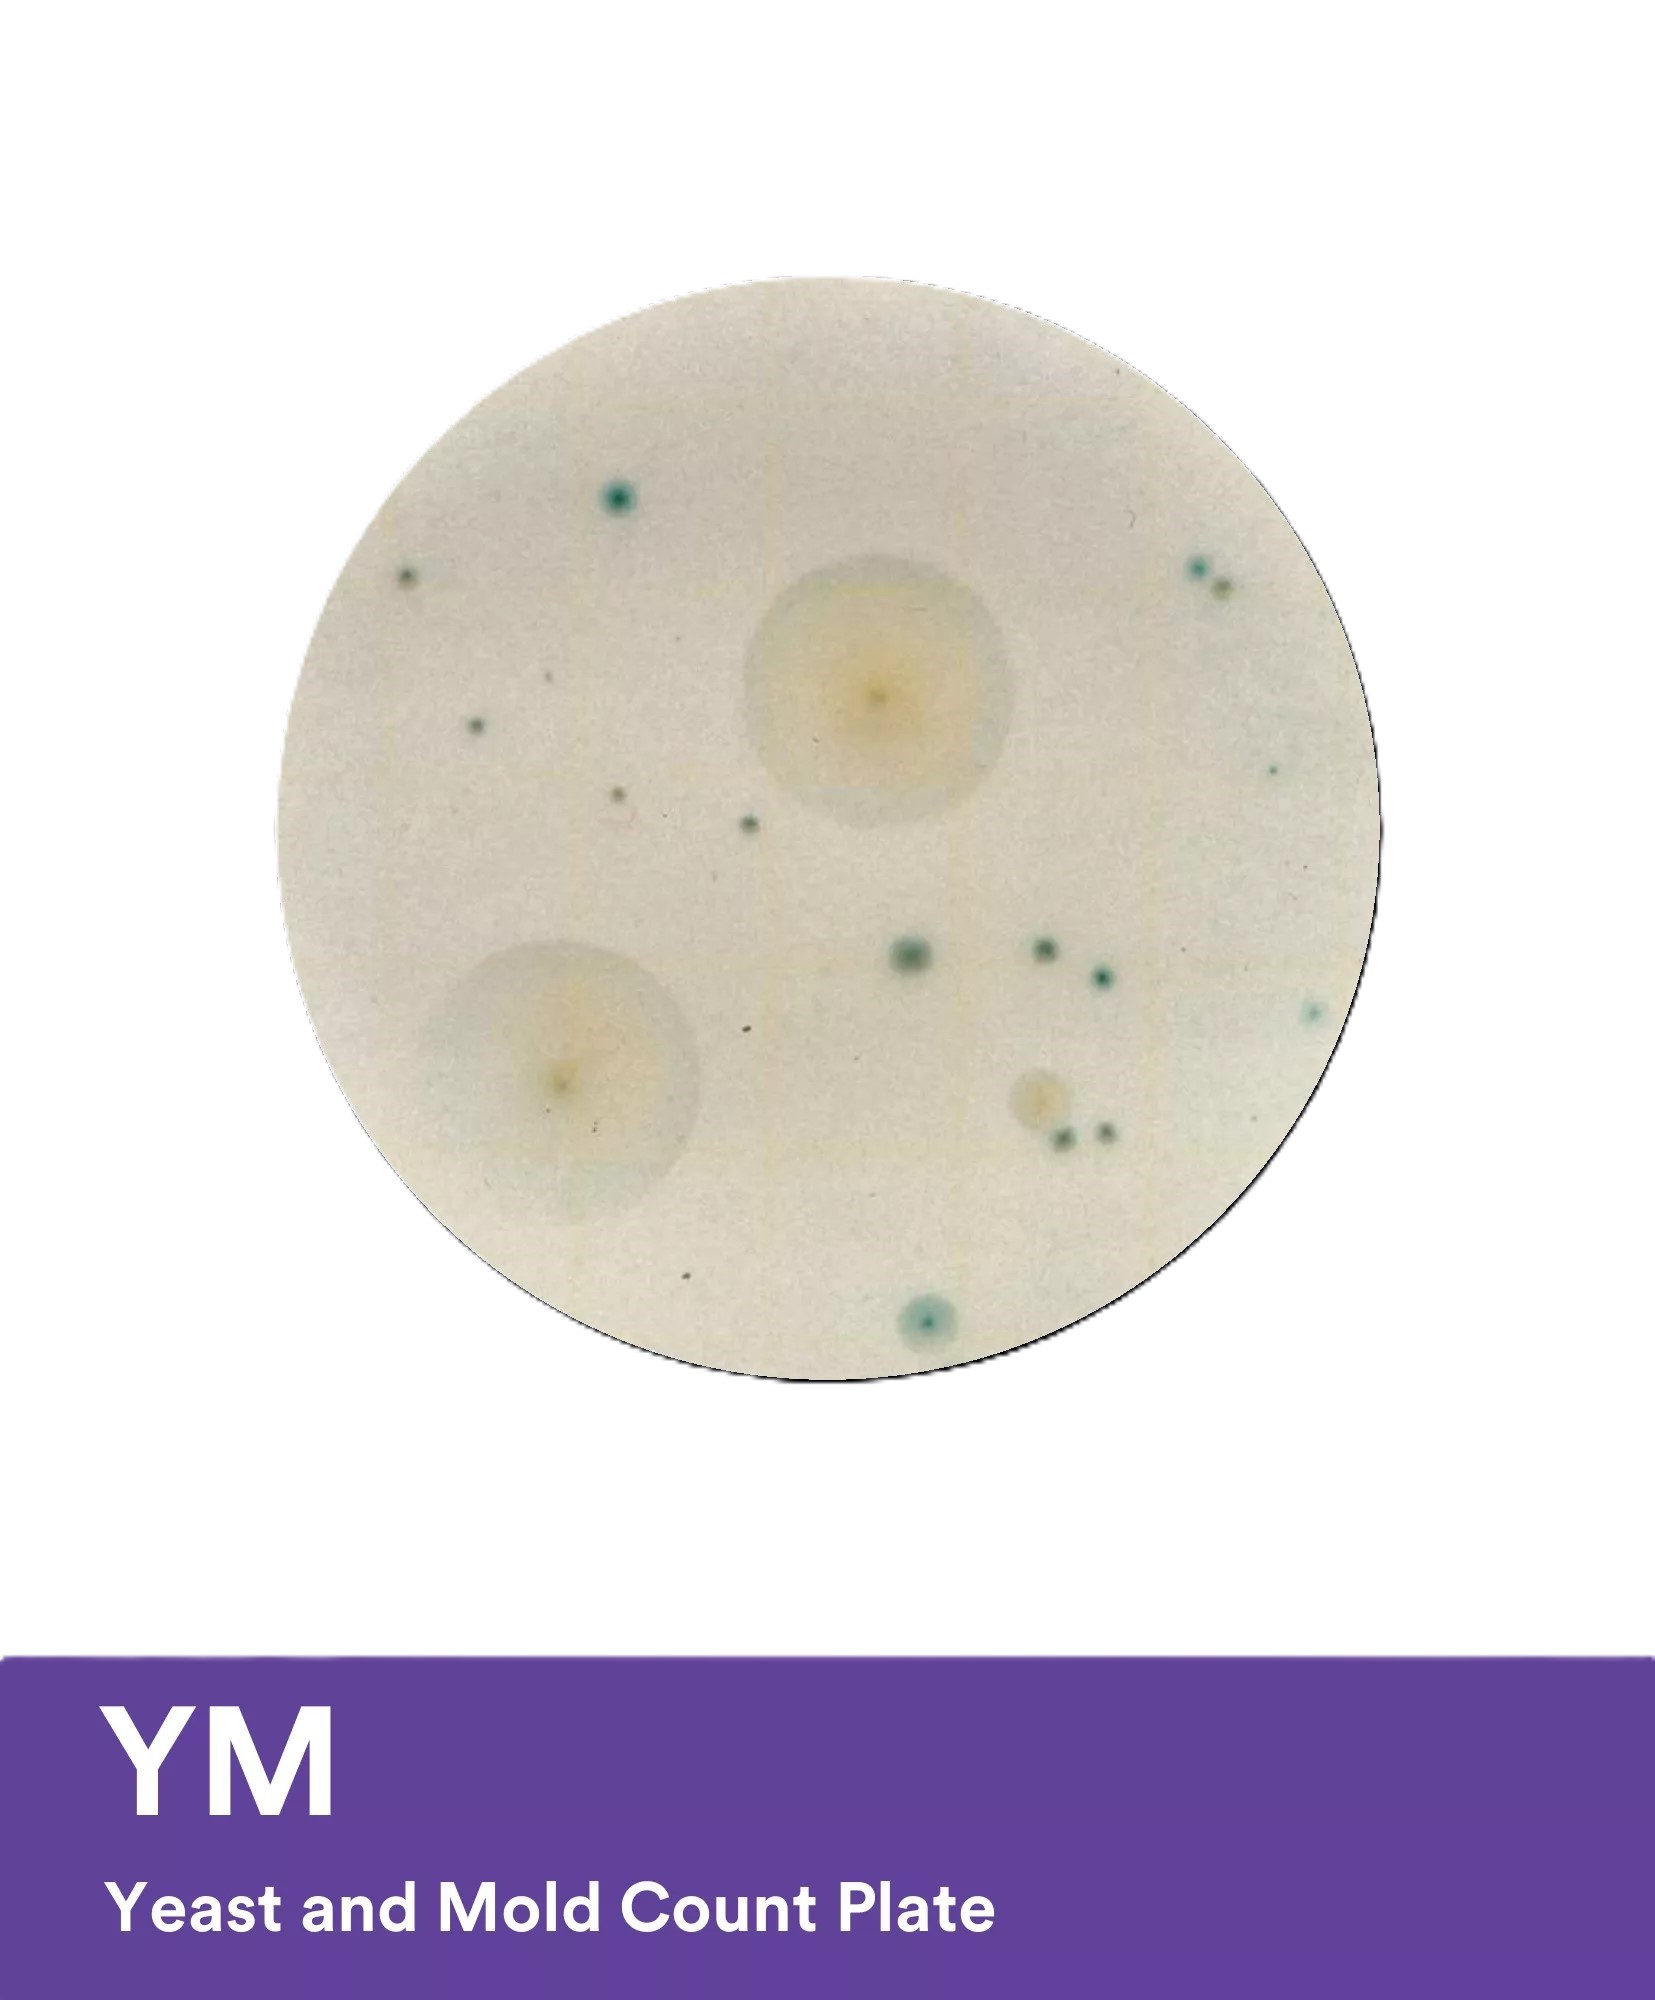
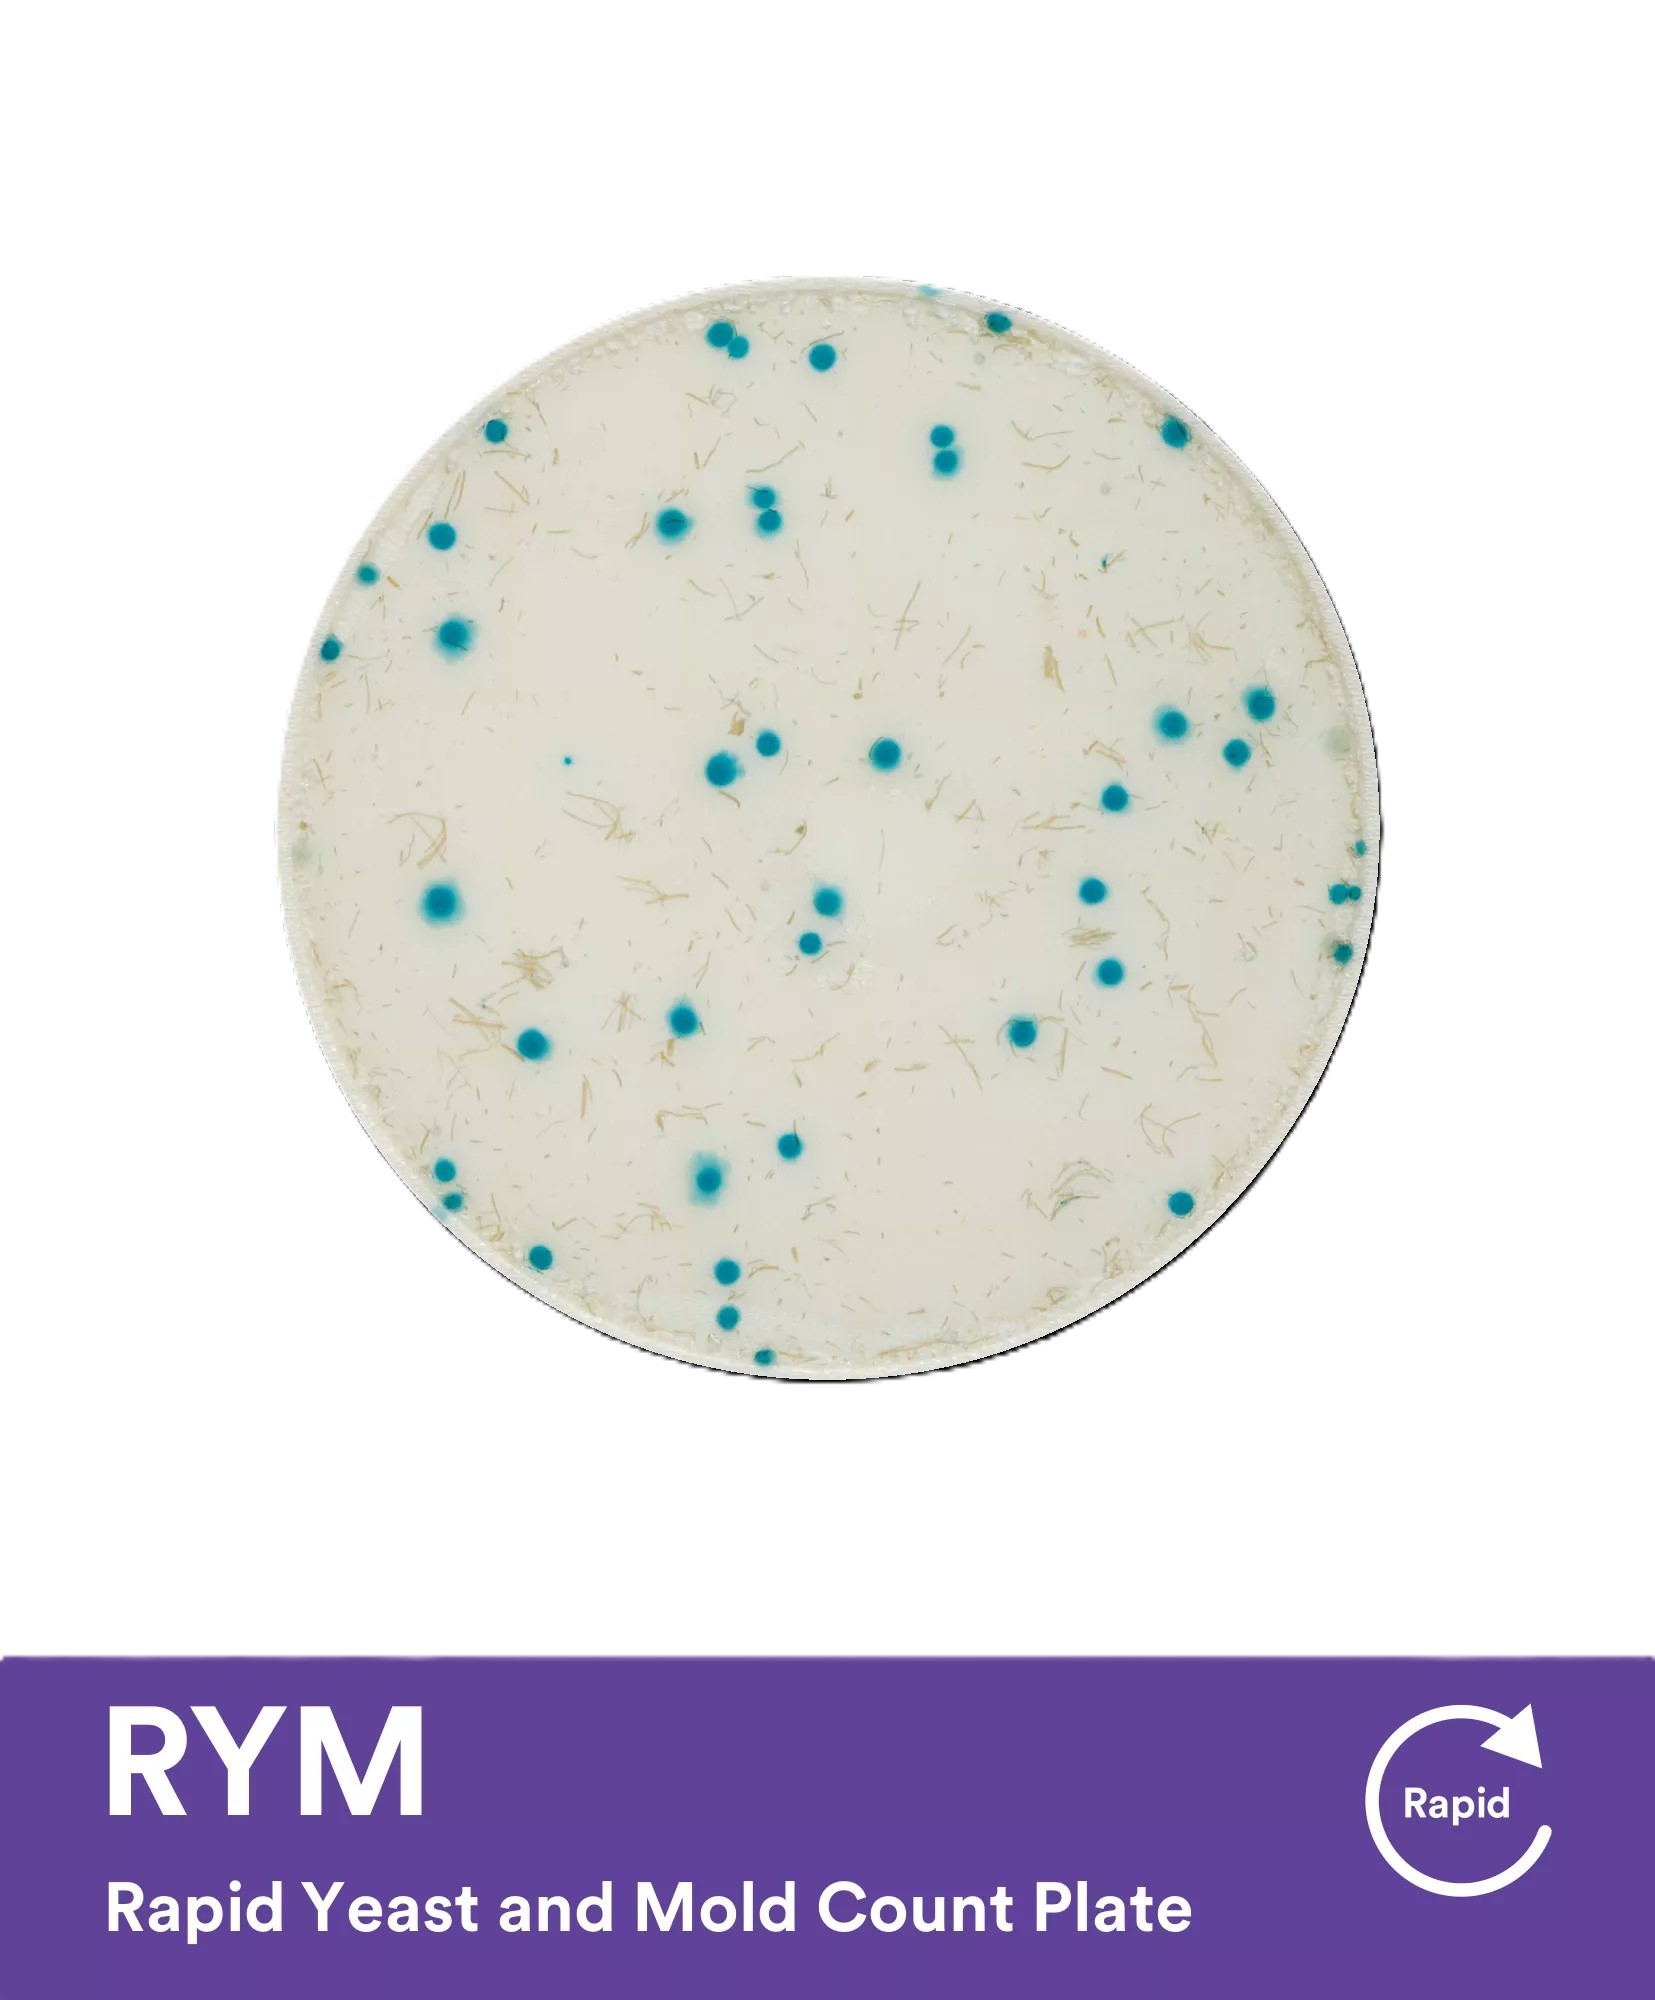

Neogen® Petrifilm® - Your Partner In Microbial Testing
Microbial Testing is Evolving. Are You Keeping Up?
Every day food safety professionals are challenged to balance accurate, reliable results with operational efficiency. For decades, industry leaders have trusted Neogen® to deliver all of that and more for their microbiological food testing needs. When you partner with Neogen Food Safety, together we can help serve up quality, safety, and value to your customers.
Petrifilm testing solutions provide an advanced approach for your quality indicator organism testing. Each slim pack offers consistent, uniform testing media. Just open it up and get right to work.
• Ready to use — reduce or eliminate time-consuming agar prep
• Proven food testing methods for consistent, reliable results
• Compact size uses less storage/incubator space
Streamline Your Workflow with Our Petrifilm Portfolio

*Reduction in Primary Energy Demand, Blue Water Consumption and Greenhouse Gas Emissions from Neogen Petrifilm Plates Compared to Traditional Microbiological Analysis Method, Neogen, 2023. **Excludes passive time (e.g. incubation time and autoclave cycles). ***Results compared to traditional agar plates.
Get Your Questions Answered by a Petrifilm Expert
Fast and accurate microbial testing, without the preparation. See how Petrifilm Plates can optimize your operation efficiency and deliver results when you need them most.
This promotion is available only in the United States and Canada from Sept 1, 2025 to Feb 28, 2026. Neogen reserves the right to modify or cancel this promotion at any time, without notice. Contact your Neogen sales representative for the full terms and conditions of this promotion.
A broad portfolio of ready-to-use plates for microbial testing
Our broad portfolio of plates delivers trusted solutions for microbiology testing, including aerobic count, yeast and mold, E.coli, and total coliform detection. Fast, simple, and reliable, they eliminate media prep and agar dishes, delivering accurate results in 18–24 hours with our rapid portfolio, or up to 48 hours, depending on your requirements.

Simplify Microbial Testing with Three Simple Steps
01 Inoculate
Eliminate media prep — plates are ready to inoculate.
02 Incubate
A compact incubator is all you need.
03 Enumerate
Use the Petrifilm Plate Reader Advanced to automate your counting process and work more efficiently.
Ready to Take Your Lab to the Next Level? Automate Your Plate Reading
Neogen Petrifilm Plate Reader Advanced
Neogen Petrifilm Automated Feeder


- Results in 6 seconds or less
- Enumerate up to 900 plates per hour
- Reduce enumeration time by up to 94%
- Recognizes 10 different barcode symbologies
- Create worklists to optimize workflow

- Automatically feeds and enumerates up to 300 Petrifilm Plates in any order in 33 minutes
- Separation station that picks and separates plates
- Continuously pushes data into an Excel file for seamless LIMS integration
Trusted by Food Science Labs
Certifications and Validations*
- AOAC ® Official Methods of Analysis℠
- AOAC ® Performance Tested Methods℠
- NF VALIDATION by AFNOR Certification
- MicroVal Certification following ISO 16140-2
- Numerous regional and local approvals
*Check individual Petrifilm Product Instructions for specific validations. **Tabulated in 2020.